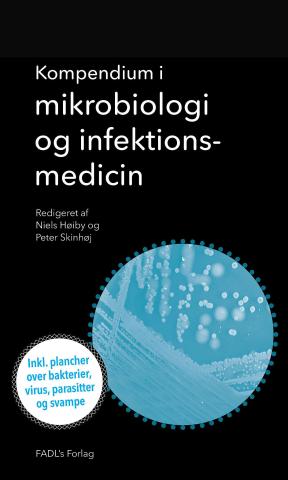
Redaktører: Niels Høiby og Peter Skinhøj. Forlag: FADL's Forlag, 2015. Sider 340. Pris: 349,95 kr.

Kompendiet i mikrobiologi og infektionsmedicin, som foreligger i 1. udgave, er en komprimeret version af lærebogen af samme navn, redigeret og skrevet af de samme forfattere og tiltænkt medicinstuderende på de danske medicinske fakulteter i forbindelse med eksamensforberedelse til fagene mikrobiologi og infektionssygdomme.
Kompendiet har en overskuelig indholdsfortegnelse, er grafisk let læseligt, med et tilknyttet Appendix med fem plancher over diverse mikrobiologiske agens og anvendelse af antibiotika. Det er skrevet i et let læseligt sprog, men det at teksten er komprimeret uden billeder, tabeller eller figurer, gør læsningen lidt tung. Eneste undtagelse hertil er en yderst anvendelig tabel over sygdomsbillede, mulig parasitær ætiologi og valg af undersøgelse, som afslutter kapitlet om parasitologi.
De første syv kapitler omhandler generel og systematisk bakteriologi, virologi, infektionshygiejne og antibiotikabehandling, mykologi og parasitologi. Kapitel 8 om infektionsmedicinske principper og strategier er meget kort (ni af bogens ca. 320 sider) og kunne med fordel udvides til at omfatte diagnostik og behandling af flere sygdomsmanifestationer end aktuelt. Ydermere indledes kapitlet med to afsnit omhandlende uddannelsen til infektionsmedicinsk speciallæge, hvilket kan virke lidt malplaceret i et kompendium af denne art, men det er en mindre detalje.
Overordnet er man grundigt opdateret, teoretisk såvel som klinisk, efter læsning af dette kompendium, som bestemt kan anbefales både eksamenslæsende medicinstuderende og andre med interesse for fagene mikrobiologi og infektionssygdomme.
Overlæge, forskningslektor, ph.d. Nina M. Weis
E-mail: ninaweis@dadlnet.dk
Interessekonflikter: Investigator, underviser eller medlem af Advisory Boards om viral hepatitis og hiv for Abbvie, Bristol-Myers Squibb, Gilead, Merck Sharp Dohme og Janssen.